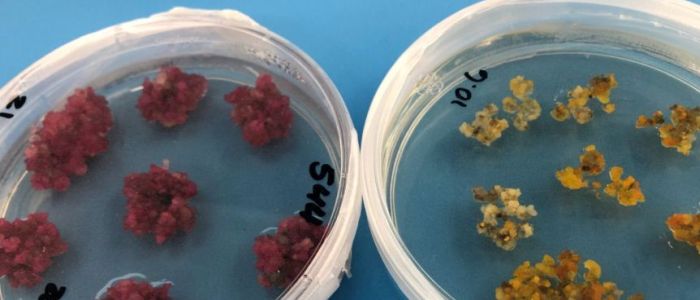
Вчені відкрили спосіб вирощувати кольорову бавовну

Вчені відкрили спосіб вирощувати кольорову бавовну
Кілька десятків чашок Петрі у високотехнологічній теплиці в Канберрі здатні перетворити світову текстильну промисловість.
Вони містять рослинну тканину, яка протягом декількох днів виросте в бавовник: не стандартний, повсякденний білий бавовна, а зі сліпучим набором кольорів.
Вони є продуктом селекціонерів CSIRO, присвячених виробництву кращих, стійких натуральних волокон, які, як ми сподіваємося, одного разу приведуть до появи зморшок, природно забарвленого еластичного бавовни, що перевершує синтетичні тканини.
Колін Макміллан очолює команду вчених, які зламали молекулярний колірний код бавовни, додавши гени, щоб змусити рослини виробляти колір.
"Якщо бавовна виробляє свій власний колір, це змінює гру", - сказав доктор Макміллан.
"Ми бачили деякі дійсно красиві яскраві жовті кольори, свого роду золотисто-оранжеві кольори, аж до деяких дійсно глибоких фіолетових", - сказала колега вченого Філомена Петтоліно.
Пройде кілька місяців, перш ніж створена ними барвиста рослинна тканина виросте у квітучі бавовняні рослини; тільки тоді вчені будуть абсолютно впевнені в успіху своїх досліджень.
Але все вказує саме на це.
Іншою позитивною ознакою є те, що кольорові бавовняні гени, впроваджені в зелені тютюнові рослини, проявляються у вигляді кольорових плям на листках.
Якщо листя біотехнологічного (генетично модифікованого) бавовни пофарбовані, то і найважливіше волокно теж буде пофарбовано.
Для вчених, які брали участь у дослідженні, це відкриття було моментом єврики.
"Коли ми побачили результати, у мене на очі навернулися сльози, тому що це був дуже особливий момент", - сказав доктор Макміллан.
А виграти для стійкості
Австралійська бавовняна промисловість, вартість якої становить близько 2 мільярдів доларів на рік, стане основним бенефіціаром.
Хоча бавовна є відновлюваною, переробленою та біорозкладаною, її все ще потрібно фарбувати, і використання іноді шкідливих хімічних барвників вважається плямою на екологічній зошиті галузі.
Особливо важлива робота команди CSIRO по виведенню натуральної чорної бавовни для заміни чорних барвників, які вважаються найбільш забруднюючими текстильні кольори.
Виконавчий директор Cotton Australia Адам Кей уважно стежить за роботою вчених.
"Ми зробили все це, щоб поліпшити наші екологічні показники, але все ж використання барвників - це те, що може вплинути на навколишнє середовище", - сказав містер Кей.
Підраховано, що в середньому кожен австралієць виробляє близько 25 кілограмів текстильних відходів на рік.
Велика його частина синтетична і потрапляє на звалище, де розкладається сотні років.
Доктор Макміллан сказала, що зростає розуміння екологічних витрат.
"Це [дослідження] дійсно може мати потенціал для перетворення світової текстильної промисловості, тому що ми виробляємо волокна, які все ще біорозкладані, все ще поновлювані, але все ще мають властивості, яких вони в цей час не мають", - сказала вона.
Доктор Петтоліно сказав, що відмова від синтетичних матеріалів на користь бавовни стане важливим кроком у справі захисту навколишнього середовища.
"Синтетичні мікроволокна в кінцевому підсумку залишаються в навколишньому середовищі і можуть завдати більшої шкоди, ніж звичайний пластик, тому важливо, щоб ми відійшли від цього, щоб захистити навколишнє середовище", - сказала вона.
Команда також працює над довгостроковим проєктом, створюючи бавовна без зморшок, яка не вимагає прасування.
Це означає скринінг і тестування тисяч бавовняних рослин, щоб перетворити їх на нові супербавовняні сорти для отримання волокна з більшою еластичністю, яке може конкурувати з синтетикою.
Назустріч біорозкладаному одягу
Сіднейський дизайнер спідньої білизни Стефані Дівайн вітає роботу, що йде в бавовняних сортах, щоб замінити синтетику.
Коли вона дізналася, що текстильна промисловість є другою за забрудненням навколишнього середовища у світі, вона організувала краудфандингову кампанію з виробництва першого компостованого бюстгальтера, який є міцним і еластичним, але не використовує синтетику.
Вона сказала, що це був величезний виклик.
- Я збирала матеріали з усього світу, - сказала міс Дівайн.
"Мені довелося знайти деревну гуму, органічну бавовну, яка еластична, тому вона добре розтягується, але також може бути з'їдена хробаками або компостована."
Незважаючи на труднощі в забезпеченні Біорозкладаних матеріалів, вона змогла зробити спідню білизну для "кругової економіки", яка може піддаватися біологічному розкладанню.
Вона сподівається, що робота CSIRO призведе до більш широких змін у галузі.
"У середньому 60% нашого одягу насправді зроблено з поліестеру, який триває 200 років на звалищі, і ми зазвичай використовуємо тільки натуральні волокна в 6% нашого одягу", - сказала вона.
"Там є реальний дисбаланс, і я думаю, що ми починаємо зміщувати це, але натуральні волокна, бавовна, вовна, Тенсел - це дійсно шлях, по якому ми повинні йти як промисловість."



